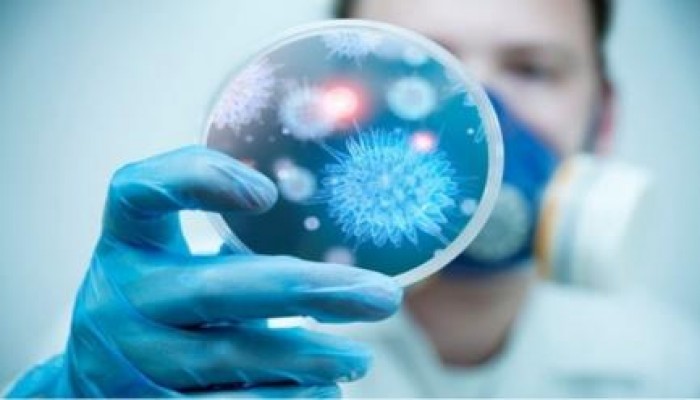
4 حالات اشتباه كورونا بالإسماعيلية

صرح مصدر مسئول بوزارة الصحة أن هناك 4 حالات اشتباه إصابة بفيروس كورونا فى محافظه الاسماعيلية حالتان منهم في مستشفى الحميات حيث انه قد تم سحب عينات من الحالات وإرسالها لوزارة للتأكد .
يأتي هذا في حالة التأهب التي تشهدها كل وزارة الصحة بجميع مديرياتها للتصدي لحالات الكورونا
الإثنين ١٨ شوّال ١٤٤٧ هـ - 6 أبريل 2026 م
أخبار النافذة
مقذوفات تضرب ميناء خورفكان في الإمارات
صاروخ إيراني يهدم مبنى في حيفا ويقتل إسرائيليين كاشفا ثغرات بالدفاعات الإسرائيلية
رئيس بلدية حيفا: سقوط الصاروخ الإيراني كان حدثًا صعبًا (فيديو)
عندما نبالغ في التهدئة.. كيف نزيد توتر أطفالنا دون أن نشعر؟
53 عامًا على اختراع أول هاتف محمول في العالم.. تعرف على قصته
التحالف الإسلامي.. هل تحقق حلم أردوغان؟
الخليج يرفض أن يكون "طبقًا سياسيًا" على مائدة الآخرين
معالم النظام الدولي الاقتصادي الجديد ما بعد دافوس 2026